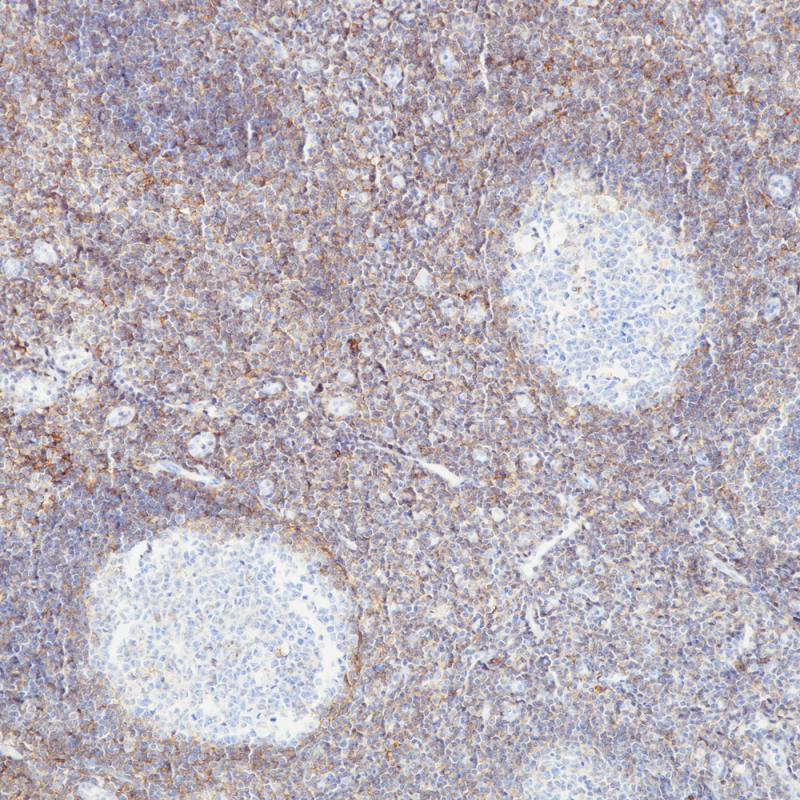

Lung Adenocarcinoma
Tonsil
CD44 Recombinant Rabbit Monoclonal Antibody
CD44 is an adhesion molecule, which binds hyaluronic acid and participates in a number of cell-cell interactions, including lymphocyte homing.
CD44 is expressed on approximately 90% of lymphocytes, monocytes, granulocytes, and, in lower amounts on thymocytes, fibroblasts, and erythrocytes.
The expression of specific cell adhesion molecule CD44 splice variants has been reported to be associated with metastasis in certain human malignancies.
CD44 is expressed on approximately 90% of lymphocytes, monocytes, granulocytes, and, in lower amounts on thymocytes, fibroblasts, and erythrocytes.
The expression of specific cell adhesion molecule CD44 splice variants has been reported to be associated with metastasis in certain human malignancies.
Specifications
- Catalog No.
- BX50127
- Clone No.
- BP6131
- Application
- IHC-P
- Subcellular location
- Membrane
- Control
- Tonsil
- Recommended method
- HIER
- Volume
- 100μl/vial, 1ml/vial
- Dilution
- 1:100-1:200
- Immunogen
- Synthetic peptide corresponding to residues within aa150 to aa250 of CD44 was used as an immunogen.
Reference
1.Mansoori M et al. Exp Mol Pathol 109:25-35 (2019).
2.Song Y et al. Sci Rep 8:16100 (2018).
Support Documents
Order
- E-mail : sales@biolynx.cn



